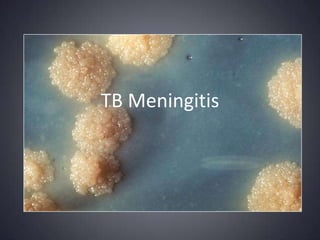
TB Meningitis

A 70-year-old male presented with a 5-year history of intermittent fever and a more recent 2-week history of behavioral changes and severe headaches. Imaging showed evidence of basilar meningitis and hydrocephalus. Cerebrospinal fluid analysis found lymphocytic pleocytosis with low glucose and high protein, consistent with tuberculous meningitis. The patient was started on empiric anti-tuberculosis treatment given the clinical suspicion while further diagnostic tests were pending. Tuberculous meningitis requires a prolonged multi-drug treatment regimen to reduce the risk of complications like hydrocephalus, infarctions, and neurological deficits.